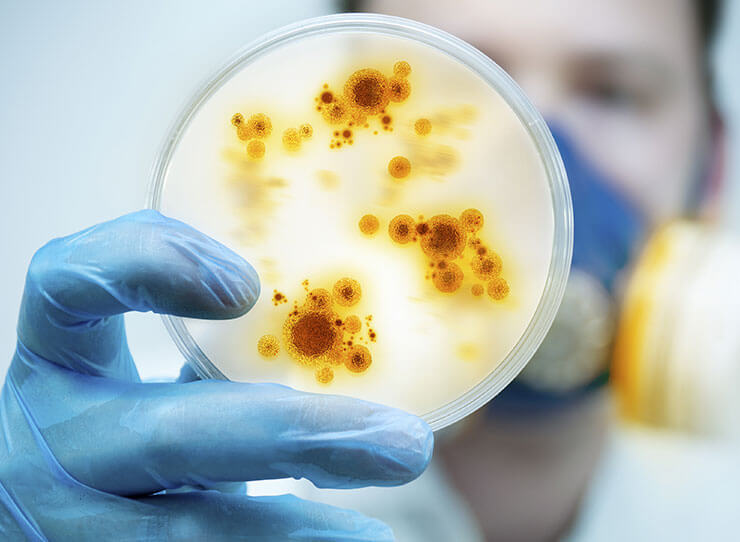

锅炉水
锅炉水Kemi科技只提供环保锅炉保护方案。这些方案包括使用高科技聚合物,高效除氧剂和油污分散剂。这些将使油污在定期排放间隔时从锅炉排出。
 冷却水
冷却水Kemi科技已经开发(所有有机的)水处理方案,能有效的防止腐蚀、沉淀和细菌问题。与未经处理的或其他公司提供的方案相比,这使我们的顾客能够选择高浓度的冷却水。这样我们的化学物质消耗、用水量、运营成本和排放量都会降低。
细菌和生物膜
细菌和生物膜Kemi科技可以通过我们供应商认可的设备为您提供生物膜和其他沉淀的在线监测。杀菌剂也能通过在线监测设备。该在线监测设备确保杀菌剂一天24小时都处于足够状态,无需担心细菌的抵抗性。
 区域供热系统
区域供热系统区域供热系统的优化保护与其他类型装置的保护并没有太大差异。关键在于重要的独立的组件会有细菌和污泥的风险。Kemi科技为各种区域供热系统提供解决方案。
 清洁
清洁如果出现问题,您可能需要对沉积物覆盖的部分进行清洁或除垢。Kemi科技为您提供清洁必需品—清洁剂,我们也提供蒸汽锅炉清洁服务(如氢氧化镁、硫酸钙沉积等),不影响机器运行。
 工艺用水
工艺用水食品厂、啤酒厂和动物饲料生产厂家会产生许多不同类型的物质,这些物质预先会被以某种方式进行热处理。这些企业通常会需要使用大量的水,Kemi可以帮助他们用水量和化学品消耗。我们使用高效环保产品,以最佳方案解决您的问题。
 水处理设备
水处理设备Kemi科技提供优质设备,投资回报率可观。我们也提供软化设备(离子交换)、导电仪控制
排水、计量泵(使用所有类型化学品)、过滤解决方案(10m3/h-100m3/h)、自检计量的试剂盒等等。
